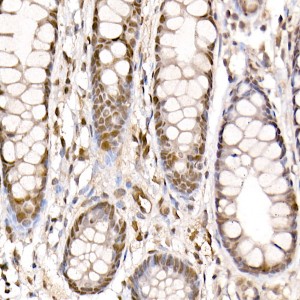
KO-Validated PRMT4/CARM1 Rabbit pAb (20 μl)

KO-Validated PRMT4/CARM1 Rabbit pAb (20 μl)
| Reactivity: | Human, Mouse, Rat |
| Applications: | WB, IHC, ELISA |
| Host Species: | Rabbit |
| Isotype: | IgG |
| Clonality: | Polyclonal antibody |
| Gene Name: | coactivator associated arginine methyltransferase 1 |
| Gene Symbol: | CARM1 |
| Synonyms: | PRMT4; M1 |
| Gene ID: | 10498 |
| UniProt ID: | Q86X55 |
| Immunogen: | Recombinant fusion protein containing a sequence corresponding to amino acids 486-603 of human PRMT4/CARM1 (NP_954592.1). |
| Dilution: | WB 1:100-1:500; IHC 1:50-1:200 |
| Purification Method: | Affinity purification |
| Concentration: | 0.27 mg/ml |
| Buffer: | PBS with 0.05% proclin300, 50% glycerol, pH7.3. |
| Storage: | Store at -20°C. Avoid freeze / thaw cycles. |
| Documents: | Manual-CARM1 polyclonal antibody |
Background
This gene belongs to the protein arginine methyltransferase (PRMT) family. The encoded enzyme catalyzes the methylation of guanidino nitrogens of arginyl residues of proteins. The enzyme acts specifically on histones and other chromatin-associated proteins and is involved in regulation of gene expression. The enzyme may act in association with other proteins or within multi-protein complexes and may play a role in cell type-specific functions and cell lineage specification. A related pseudogene is located on chromosome 9.
Images
 | Western blot analysis of lysates from wild type (WT) and PRMT4/CARM1 knockout (KO) 293T cells, using [KO Validated] PRMT4/CARM1 Rabbit pAb (A2246) at 1:500 dilution. Secondary antibody: HRP-conjugated Goat anti-Rabbit IgG (H+L) (AS014) at 1:10000 dilution. Lysates/proteins: 25μg per lane. Blocking buffer: 3% nonfat dry milk in TBST. Detection: ECL Basic Kit (RM00020). Exposure time: 180s. |
 | Immunohistochemistry analysis of paraffin-embedded Human colon using [KO Validated] PRMT4/CARM1 Rabbit pAb (A2246) at dilution of 1:20 (40x lens). High pressure antigen retrieval performed with 0.01M Citrate Bufferr (pH 6.0) prior to IHC staining. |
 | Immunohistochemistry analysis of paraffin-embedded Mouse liver using [KO Validated] PRMT4/CARM1 Rabbit pAb (A2246) at dilution of 1:20 (40x lens). High pressure antigen retrieval performed with 0.01M Citrate Bufferr (pH 6.0) prior to IHC staining. |
 | Immunohistochemistry analysis of paraffin-embedded Rat kidney using [KO Validated] PRMT4/CARM1 Rabbit pAb (A2246) at dilution of 1:20 (40x lens). High pressure antigen retrieval performed with 0.01M Citrate Bufferr (pH 6.0) prior to IHC staining. |
You may also be interested in: